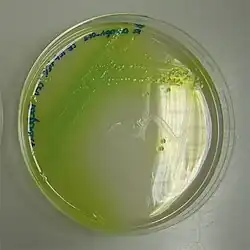
Photograph of a petri dish showing P. aeruginosa with yellow-green Pycocyanin-pigment on cetrimid agar-agar

Cetrimide agar
Cetrimide agar is a type of agar used for the selective isolation of the gram-negative bacterium, Pseudomonas aeruginosa.[1] As the name suggests, it contains cetrimide, which is the selective agent against alternate microbial flora.[2][3] Cetrimide also enhances the production of Pseudomonas pigments such as pyocyanin and pyoverdine, which show a characteristic blue-green and yellow-green colour, respectively.[4][5]
Cetrimide agar is widely used in the examination of cosmetics, pharmaceuticals and clinical specimens to test for the presence of Pseudomonas aeruginosa.[1]
References
- ^ a b http://www.bd.com/ds/productCenter/297882.asp "Cetrimide Agar Base • Pseudosel Agar". Accessed May 3, 2008.
- ^ "Pseudomonas Selective Agar, Base (Cetrimide Agar)". Archived from the original on 2008-03-25. Retrieved 2008-05-03. "Pseudomonas Selective Agar, Base (Cetrimide Agar)". Accessed May 3, 2008.
- ^ Lowbury, E. J. (1951-02-01). "Improved Culture Methods for the Detection of Ps. pyocyanea". Journal of Clinical Pathology. 4 (1): 66–72. doi:10.1136/jcp.4.1.66. ISSN 0021-9746. PMC 1023358. PMID 16810909.
- ^ http://www.sigmaaldrich.com/etc/medialib/docs/Fluka/Datasheet/14521dat.pdf "14521 Cetrimide Agar Plates". Accessed May 3, 2008.
- ^ http://www.condalab.com/pdf/1102.pdf "Cetrimide Agar Base". Accessed May 3, 2008.